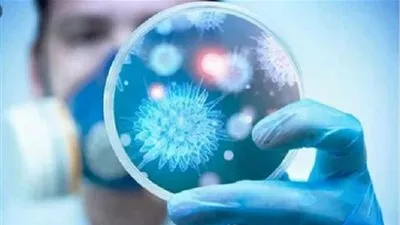
إيطاليا تعلن إلغاء مهرجان البندقية السنوي بسبب فيروس

عاجل
شاهد الآن.. ليفربول يواجه برايتون في كأس الاتحاد الإنجليزي 2025-2026
بيراميدز يواجه باور ديناموز اليوم.. البث المباشر في دوري أبطال إفريقيا
بيراميدز يواجه باور ديناموز.. كل ما تريد معرفته عن مباراة اليوم والقنوات الناقلة والتشكيل المتوقع
الأهرام ضد باور ديناموز.. موعد مباراة بيراميدز وباور ديناموز في دوري أبطال إفريقيا والقنوات الناقلة والتشكيل المتوقع
بالصور.. ديسكو مصر و"واما" ولولا جفان يتألقون في عيد الحب بنويبع